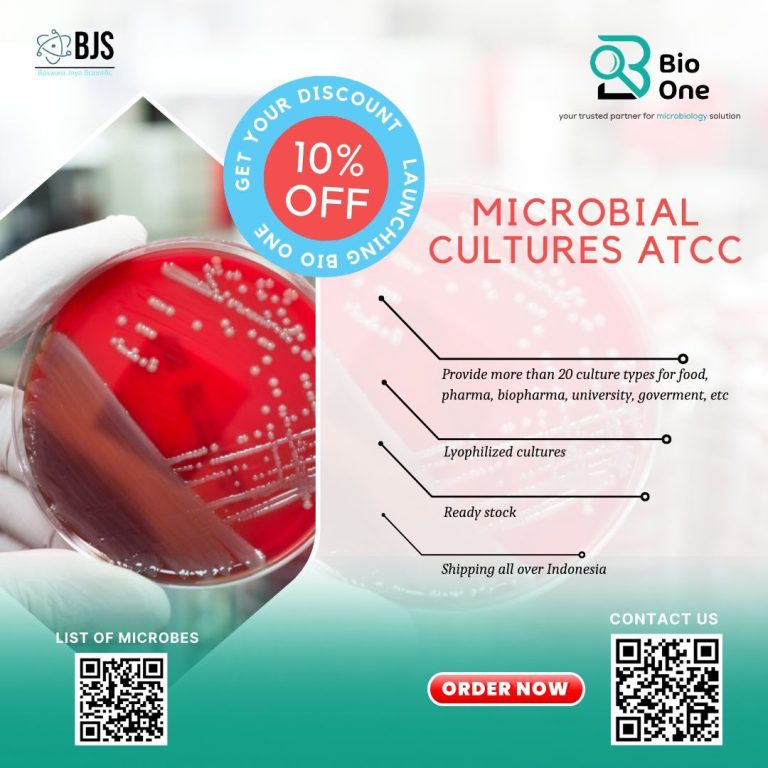

PROMO

Bawara Jaya Scientific merupakan perusahaan distributor alat laboratorium , reagent dan consumable. Kami menawarkan Kerjasama secara berkelanjutan dengan pelanggan, karena kami tidak hanya menyediakan alat dan bahan, namun kami juga melayani pelatihan, instalasi, Kontrak pemeliharaan alat.
© 2026 PT Baswara Jaya Scientific
Powered by Komersial Lab
